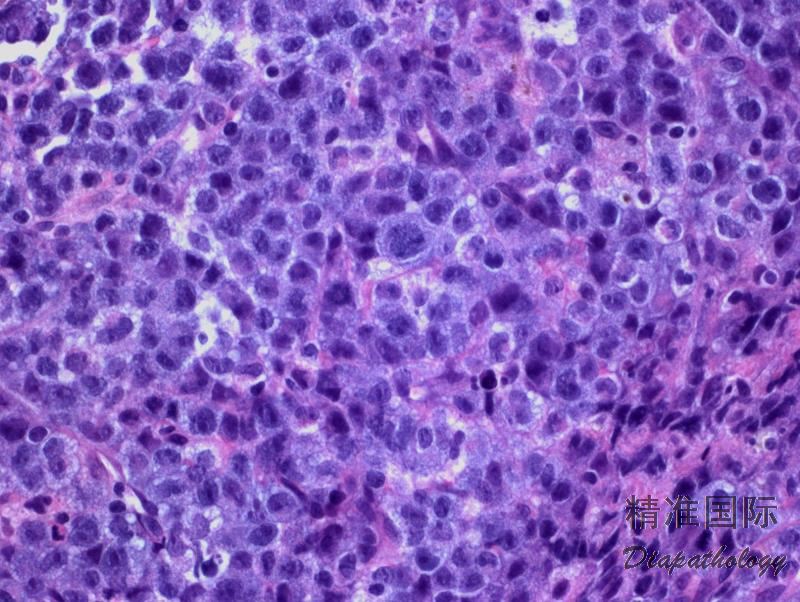

间变大细胞淋巴瘤,ALK 阳性
Anaplastic Large Cell Lymphoma, ALK+
概述:
ALCL 是一类 T 细胞淋巴瘤,通常由胞质丰富、常为马蹄形的大而多形性细胞核的肿瘤细胞构成。肿瘤细胞 CD30+,大多数病例也细胞毒分子和 EMA。根据是否有 ALK 基因易位和表达 ALK 蛋白,分为 ALK 阳性 ALCL 和 ALK 阴性 ALCL,两者形态学和免疫学基本相同,但属不同的疾病实体。ALCL(ALK+或 ALK-)必需与原发性皮肤 ALCL 及其它具有间变特征或者表达 CD30 的 T 细胞或 B 细胞淋巴瘤亚型相鉴别。
诊断要点:
多为 30 岁前发病,表现为进展期疾病,B 症状。累及淋巴结和结外部位(皮肤、骨髓、软组织、肺和肝)。
肿瘤细胞弥漫增生,常呈粘附性生长和窦内寝润。
肿瘤细胞形态谱系较宽,从主要是较小细胞到全是异性大细胞。根据肿瘤细胞大小、形态、浸润方式和背景细胞成分等分为多种模式。多数病例(常见模式,占 60%)由多形性大细胞构成,细胞胞质丰富、常透明、嗜碱性或嗜酸性,核染色质通常细块状或散在分布,可有多个核仁。此外,还有小细胞模式(5-10%),淋巴组织细胞模式(10%),霍奇金样模式(3%),或混合/复合模式(15%)。偶有病例肿瘤细胞稀少,伴背景粘液样改变,或有很多梭形细胞,呈现肉瘤样改变。无论什么生张模式,都含有数量不等的 CD30+“标志性细胞”,其形态特征为异型大细胞含偏位马蹄样或肾形核,核周常有嗜酸性区域。
免疫表型:CD30+(胞膜和高尔基区,大细胞强阳性,较小的肿瘤细胞可以弱阳性甚至阴性),ALK+(核和胞质、胞质、胞膜),EMA+/-,TIA1+/-,粒酶+/-,穿孔素+/-,CD4+/-,CD43+/-,CD3-/+,CD5-/+,CD7-/+,CD45-/+,LMP-1-, EBER-。
TCR 基因克隆性重排。
染色体易位累及 ALK 基因位点(2p23),最常见 t(2;5)(p23;q35) /ALK-NPM(>80%),其次是变异型易位 t(1;2)(q25;p23)/TPM3-ALK(>10%),还有很多种累及其它伙伴基因的变异型易位。此外,还常有继发的染色体异常。
亚型:
- 普通型 ALCL :最多见(60%)。肿瘤由多形大细胞包括标志性细胞构成,但也可是较单一的卵圆形核细胞混合多形型大细胞,通常呈粘附性生长,可见特征性窦内浸润。
- 淋巴组织细胞型 ALCL :较少见(10%)。特征是大量组织细胞增生(小圆核,嗜酸胞质),甚至掩盖混于其中的肿瘤细胞。肿瘤细胞通常小于普通型的肿瘤细胞,常呈簇状分布于血管周围。可以通过免疫组化(CD30,ALK 等)帮助识别。
- 小细胞型 ALCL :较少见(5-10%)。肿瘤由小至中等大小的细胞构成,核不规则或圆形,但总是能找到少量标志性细胞,通常围绕血管。小细胞免疫组化(CD30,ALK 等)常阴性,但大细胞和标志性细胞阳性,有助诊断。
- 何杰金样型 ALCL :少见(3%)。形态类似 NSCHL,纤维化和模糊结节,HRS 样细胞及标志性细胞。CD30+ 和 ALK+ 有助诊断。
- 复合型 ALCL :较少见(15%)。存在一种以上形态学特征。
- 肉瘤样型 ALCL: 最少见(1%)。肿瘤细胞呈梭形伴粘液水肿样背景。

免疫组织化学染色:
CD30+(胞膜和高尔基区),ALK+(核和胞质、胞质、胞膜),EMA+/-,TIA1+/-,粒酶+/-,穿孔素+/-,CD4+/-,CD43+/-,CD3-/+,CD5-/+,CD7-/+,CD45-/+,LMP-1-,EBER-。
分子标记:
染色体易位累及 ALK 基因位点(2p23),最常见 t(2;5)(p23;q35) /ALK-NPM(>80%)和 t(1;2)(q25;p23)/TPM3-ALK(>10%)
鉴别诊断:
转移瘤 :转移瘤可呈现窦内寝润,有的表达 EMA(癌)或 CD30(胚胎性癌),易与 ALCL 混淆。但转移瘤同时表达别的有关抗体(如 CK),且不表达 ALK。
外周 T 细胞淋巴瘤** **,非特指(PTCL,NOS):细胞通常不具间变性,也很少窦内浸润。 虽有的病例 CD30 阳性,但一般较弱或局灶阳性,ALK 阴性。
间变性大细胞淋巴瘤,ALK 阴性 (ALCL,ALK-):形态学和免疫学与 ALCL,ALK +相似,但不表达 ALK。预后较差。
经典型霍奇金淋巴瘤 (CHL):需与霍奇金样型 ALCL 相鉴别。CHL 中的 HRS 细胞 CD30 +、CD15+/-、PAX5+、CD20-/+、 EMA-、 ALK-。
ALK+ 弥漫大 B 淋巴细胞瘤 (ALK+ DLBCL):肿瘤细胞弥漫增生,形态相对均一,表现为浆母细胞样或免疫母细胞样。免疫表型:ALK+,CD138+,IgA+,CD30-。
原发性皮肤 ALCL :常表现为单个皮肤结节或肿块伴溃疡。形态学和免疫学与系统性 ALCL 相似,但一般不表达 ALK(有极少数原发于皮肤的 ALK+ ALCL 的报道)。
炎性肌纤维母细胞瘤 (inflammatory myofibrolastic tumor):可表达 ALK,但 CD30 阴性,T 细胞相关抗原阴性,无标志性细胞。
ALK+ 系统性组织细胞增生症: 是一种发生于早期婴儿的罕见系统性组织细胞增生症,形态学为大组织细胞,与 ALCL 肿瘤细胞不同;免疫学上表达 CD68 和 ALK,但不表达 CD30。
预后:
典型和变异型 ALK 基因易位在预后上没差别,长期生存达 80%。总体预后较 ALK 阴性 ALCL 要好,但大于 40 岁患者年龄组中,两者预后没有差别。因此,ALK 阴性 ALCL 患者总体预后较差的原因也可能是其总体发
← 严重蚊虫叮咬过敏 原发皮肤间变大细胞淋巴瘤 →
